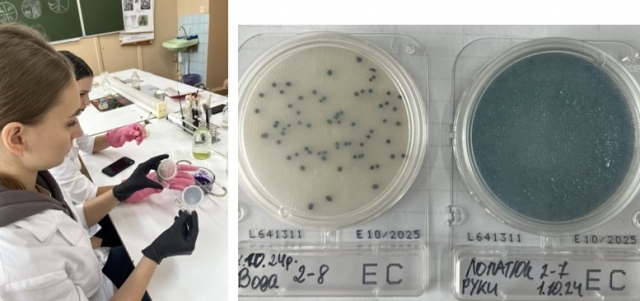

Практичні заняття студентів спеціальності «Громадське здоров'я» з дисципліни «Мікробіологія, вірусологія та імунологія»
У рамках навчальної дисципліни «Мікробіологія, вірусологія та імунологія» студенти спеціальності «Громадське здоров'я» активно займаються вивченням мікробіології, що відіграє ключову роль у розумінні процесів, що впливають на здоров'я населення.
 (Фото з архіву кафедри)
(Фото з архіву кафедри)
Практичні заняття з мікробіології спрямовані на формування у студентів навичок роботи з мікробними культурами, вивчення їх властивостей тощо. Також навчаються проводити аналізи на наявність різних груп мікроорганізмів в матеріалах, використовуючи класичні та сучасні методи; визначають резистентність мікроорганізмів до протимікробних засобів; вивчають роль мікроорганізмів в екосистемах та їх вплив на здоров'я людини.
Значну зацікавленість у здійсненні лабораторних досліджень у студентів викликає можливість відпрацьовувати свої навички з використанням хромогенних пластинок Compact Dry (Японія) для кількісного визначення бактерій різних видів в продуктах харчування, косметиці, воді, змивах з поверхонь або сировині.
(Фото з архіву кафедри)
(Фото з архіву кафедри)
Вивчення нормальної і патогенної мікрофлори людини та навколишнього середовища допоможе майбутнім фахівцям у галузі громадського здоров'я оцінювати ризики та впроваджувати заходи профілактики захворювань.
Практичні заняття з мікробіології є невід'ємною частиною підготовки фахівців у галузі громадського здоров'я. Вони сприяють розвитку критичного мислення, наукового підходу та практичних навичок, необхідних для ефективної роботи в галузі охорони здоров'я.
Особлива подяка за допомогу в організації матеріалів для проведення практичних занять декану факультету харчових технологій та управління якістю продукції АПК, д. техн. н., професору Баль-Прилипко Ларисі Вацлавівні та заступниці декана з навчальної роботи, к. с.-г. н., доценту Слободянюк Наталії Михайлівні.
Ганна Козловська,
Марія Мельник,
доценти кафедри ветеринарної епідеміології
та охорони здоров’я тварин
